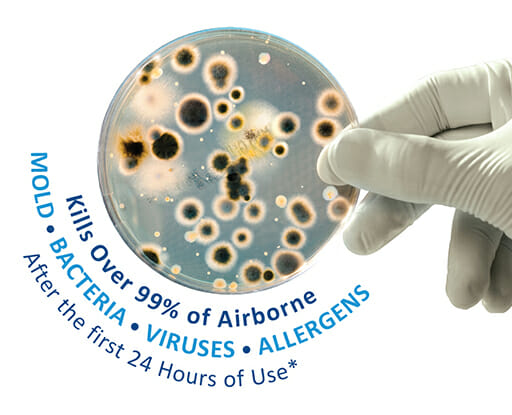
infectious-diseases

Kill Viruses, Germs, and Improve Your Home’s Air Quality So You Can Breathe Easy
Kill Viruses, Germs, and Improve Your Home’s Air Quality So You Can Breathe Easy
A variety of IAQ products, including air-scrubbers, UV Lights, and filters, have been in the spotlight recently due as more and more people look to make the air inside their home as safe as possible. But not all products are created equally and many products need to be sized for your particular home and HVAC system.
So what’s a homeowner to do? Call the experienced professionals at John Moore and request a free Indoor Air Quality Assessment, which includes a consultation with a TACL licensed professional and a step-by-step IAQ inspection of your home. From there, we will recommend the best options to improve the air in your home from our extensive line of HEPA filters, air purifiers, and UV products.
How UV Light Kills Viruses
For over a century, scientists have known that certain types of UV Light is harmful to microbial life. In fact, exposure to a specific kind of ultraviolet light (the UV-C band) actually disrupts the DNA of micro-organisms and preventing them from reproducing, thereby effectively killing them. Also, the UV-C band is filtered out by the Earth’s atmosphere, so microbes have no defense again it.
Installing a UV light in your home’s HVAC system helps keep your HVAC coil clean and free from mold and other microbes which would then circulate in the air throughout your home, and it increases the efficiency and longevity of your unit.

The Best Combo = UV + Filtration + Purification
In order to properly address the overall quality of the air in your entire home, however, you need more than just a UV Light. Adding a filter and air purifier to a UV light system, enables you to remove 99% of bacteria, viruses, air borne allergy particles, as well as unwanted odors from the home. The increased volume and capacity of this solution allows you to address your home’s air quality on a larger scale and effectively sanitize the air circulating throughout your home.
Similar air cleaning technologies have been used in hospitals and other commercial settings for years, and it is now available for residential use. In fact, John Moore has installed this technology in our own HVAC systems to help our essential employees healthy and safe.
Please note: Some popular “air-scrubbing” solutions produce ozone as a by-product of the cleaning process, and some have reported irritation and a strong smell from the ozone gas being in their home’s air. That’s why John Moore is proud to offer award-winning IAQ products that are just as effective at sanitizing the air, without introducing unwanted ozone into your home.
Take The First Step to Filtered, Sanitized, and Healthier Air Inside Your Home
Contact the IAQ specialists at John Moore to set up your FREE Indoor Air Quality Assessment and ask any questions that you may have regarding your home’s air quality in light of recent health concerns. We’re at your service and here to help you breathe easier. Call us at (713) 730-2525 or book online today!
Share this Post